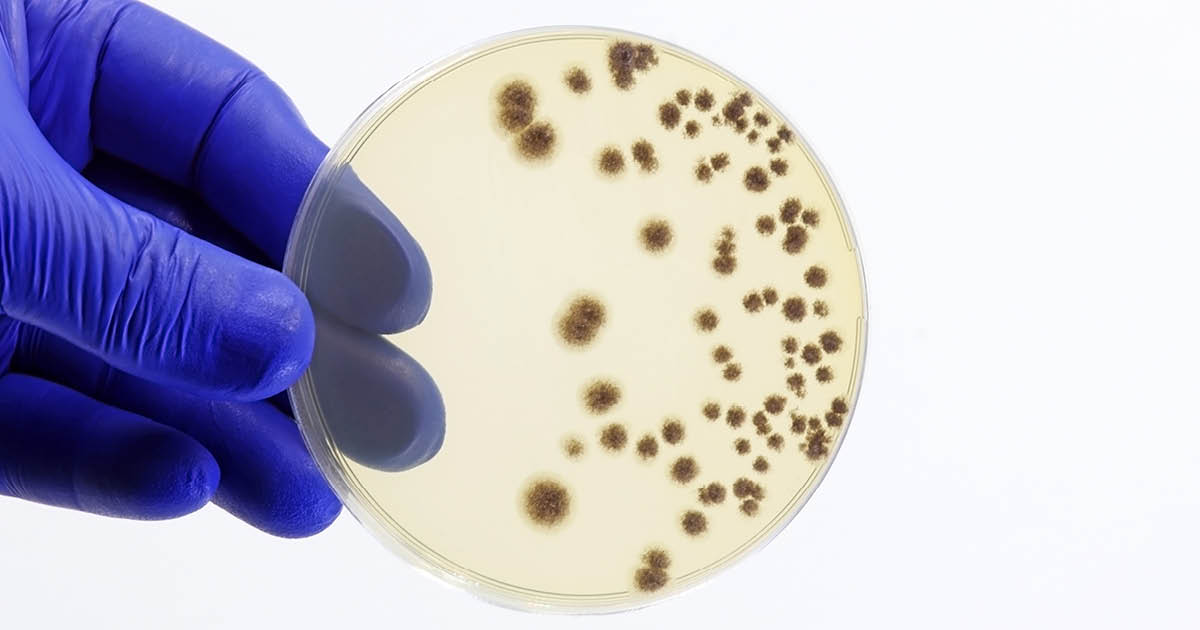
IDN0124Huggins_Graphic_01

Study shows risk for invasive fungal infection after lung transplant is ‘very complex’
January 02, 2024
2 min read
Add topic to email alerts
Receive an email when new articles are posted on
Please provide your email address to receive an email when new articles are posted on .
”
data-action=”subscribe”>
Subscribe
We were unable to process your request. Please try again later. If you continue to have this issue please contact [email protected].
Back to Healio
Key takeaways:
- Among patients with IFI, yeast on donor culture and prolonged length of stay were associated with early IC risk.
- Transplantation in 2016 or 2017 and female recipient sex were associated with reduced risk.
Researchers found that risk factors of invasive fungal infections for lung transplant recipients receiving universal antifungal prophylaxis varied in terms of early and late infection and invasive mold- and candidiasis-type infections.
“Past studies have helped to establish important risk factors for invasive fungal infections (IFI) among lung transplant recipients,” Jonathan P. Huggins, MD, MSCE, assistant professor of medicine at Duke University, told Healio. “Here we sought to build on this understanding by addressing several unanswered questions.”

A high proportion of patients were diagnosed with invasive fungal infections following lung transplantation, including invasive candidiasis. Image: Adobe Stock.
According to Huggins the team aimed to understand how risk factors for invasive candidiasis (IC) differ from those for invasive mold infection (IMI) and whether risk factors for mold infection occurring early after lung transplantation differ from IMI occurring late after lung transplantation.
“Duke uses a universal antifungal prophylaxis strategy for lung transplant recipients,” he added. “Not many studies have examined risks for IFI in the context of universal prophylaxis. As a high-volume transplant center, we felt we were uniquely equipped to answer some of these questions.”
Huggins and colleagues conducted a retrospective, single center, cohort study assessing 603 lung transplant recipients for risk factors for IC and IMI within 90 days of transplant and late IMI 90 days to a year after transplant.
Overall, the study showed that 159 (26.4%) patients had 182 IFIs. Huggins noted that this is a “high rate” and could be partly due to a “geographic phenomenon” and should “serve as a reminder that readers of this study, as with any other study of infectious risk, should take their center’s local epidemiology into account before drawing any conclusions about the generalizability of the results.”
That said, however, Huggins explained there were many interesting findings, including that among these patients, growth of yeast on donor culture (HR = 3.3; 95% CI, 1.89-5.75) and prolonged length of stay (HR = 1.02; 95% CI, 1.01-1.03) were associated with early IC risk. The study also showed that transplantation in 2016 (HR = 0.21; 95% CI, 0.06-0.7) or 2017 (HR = 0.25; 95% CI, 0.08-0.8) and female recipient sex (HR = 0.53; 95% CI, 0.3-0.93) were associated with reduced risk.
Among patients with IMI, anti-mold therapy (HR = 0.21; 95% CI, 0.06, 0.78) was associated lower early IMI risk and female donor sex (HR = 0.4; 95% CI, 0.22, 0.72) was associated with lower late IMI risk, whereas recent rejection was a risk factor for late IMI (HR = 1.73; 95% CI, 1.02-2.95) and renal replacement therapy predisposed to early IC (HR = 5.67; 95% CI, 3.01-10.67), early IMI (HR = 7.54; 95% CI, 1.93-29.45) and late IMI (HR = 5.33; 95% CI, 1.46-19.49).
“This study raises several interesting questions for further study, but I think the take-home message for clinicians is that risk for IFI after lung transplantation is very complex,” Huggins said. “Local epidemiology is important to consider, but so too are institutional practices such as the antifungal prophylaxis strategy employed.”
Published by:
Sources/Disclosures
Collapse
Disclosures:
Huggins reports no relevant financial disclosures. Please see the study for all other authors’ relevant financial disclosures.
Add topic to email alerts
Receive an email when new articles are posted on
Please provide your email address to receive an email when new articles are posted on .
”
data-action=”subscribe”>
Subscribe
We were unable to process your request. Please try again later. If you continue to have this issue please contact [email protected].
Back to Healio